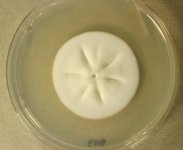
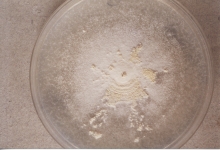

Search Details
| UAMH Number: | 9666 |
|---|---|
| Species Name: | Nannizziopsis crocodili |
| Type: | Nannizziopsis crocodili |
| Synonyms: | |
| Taxonomy: | FUNGI Ascomycota, Eurotiomycetes, Onygenales, Nannizziopsidaceae |
| Strain History: | Thomas, A. (9744993 - 3B) -> UAMH |
| Substrate: | plaque-like skin lesion on crocodile (Crocodylus porosus); histopathology + for hyphae and arthronconidia | Location: | AUSTRALIA Gulf of Carpentaria, Edward River (GEO: -14.771,142.309) |
| Isolator: | |
| Isolation Date: | 1999 |
| Date Received: | 1999-12-02 |
| Characters: | CYCLOHEXIMIDE resistant (MYC) - // HUMAN/ ANIMAL PATHOGEN fatal cutaneous mycosis in saltwater crocodile - Thomas, Sigler, Peucker, Norton & Nielan, Med. Mycol. 40:143-151, 2002 // MESOPHILIC NG @ 37C - // MOLECULAR SYSTEMATICS phylogeny of Nannizziopsis and reptile pathogens belonging to the CANV complex - Sigler L, Hambleton S, Pare JA, J Clin Microbiol 51:3338-3357, 2013 (Click for publications citing UAMH 9666) |
| Compounds: | |
| Cross Reference: | |
| Collections: | Living Strains; Dried Herbarium Material |
| Pathogenic Potential: | Human: no | Animal: yes | Plant: no |
| Biosafety Risk Group: | RG2 (check the PHAC ePATHogen Risk Group Database for updates) |
| Regulatory Requirements: | Canadian requesters must provide PHAC Pathogen and Toxin License Number (see: https://www.canada.ca/en/public-health/services/laboratory-biosafety-biosecurity/licensing-program.html) and a CFIA Written Authorization for transfer (http://www.inspection.gc.ca/plants/plant-pests-invasive-species/directives/date/d-12-03/eng/1432656209220/1432751554580#app2) prior to shipment. International requesters must provide all legally required importation documentation prior to shipment. Plant pathogenicity status may be verified by using the USDA Agricultural Research Service (ARS) Fungal Database |
| MycoBank ID: | 804605 |
| Sequences: | >UAMH09666_NR111876 CATTACTGTTGGCTCCCGGGAGCGCCCTCGGGCACCCCGGACCCTCCACCCGTGTCTACCGAACCATATACTGCCTCGGCGGGCCCGTCTTCGGGCTGCTGGGACCCGCGGGCCTCCCCTCCAGCGATGGGGGCGGTGGTCCCCGGGCCCGGGCATGCGCCCGCCGCTGGCCCCCCTGAACTTCGTGAACAGTGAGCAGTCTGAGTGAGATTTTCAATCGTTTAAAACTTTCAACAATGGATCTCTTGGTTCCCGCATCGATGAAGAACGCAGCGAAATGCGATAACTAATGTGAATTGCAGAATTCCGTGAATCATCGAGTCTTTGAACGCACATTGCGCCCCCTGGTATTCCGGGGGGCATGCCTGTCCGAGCGTCATTGCACCCCTCAAGCACGGCTTGGTGTTGGGCGACCGTCCCCCGGGACGCGCCCCAAATGCATTGGCGGCACCGGCCCCGGTGTCCGGAGCGTATGGGAGACCTGTCACGCCCGTAGGACCCGGTCGGCGCTGGCCTTGACCTCAGTTCATCTCCAGGTTTGACCTCGGATCAGGTAG >UAMH09666_NR111876_ITS CATTACTGTTGGCTCCCGGGAGCGCCCTCGGGCACCCCGGACCCTCCACCCGTGTCTACCGAACCATATACTGCCTCGGCGGGCCCGTCTTCGGGCTGCTGGGACCCGCGGGCCTCCCCTCCAGCGATGGGGGCGGTGGTCCCCGGGCCCGGGCATGCGCCCGCCGCTGGCCCCCCTGAACTTCGTGAACAGTGAGCAGTCTGAGTGAGATTTTCAATCGTTTAAAACTTTCAACAATGGATCTCTTGGTTCCCGCATCGATGAAGAACGCAGCGAAATGCGATAACTAATGTGAATTGCAGAATTCCGTGAATCATCGAGTCTTTGAACGCACATTGCGCCCCCTGGTATTCCGGGGGGCATGCCTGTCCGAGCGTCATTGCACCCCTCAAGCACGGCTTGGTGTTGGGCGACCGTCCCCCGGGACGCGCCCCAAATGCATTGGCGGCACCGGCCCCGGTGTCCGGAGCGTATGGGAGACCTGTCACGCCCGTAGGACCCGGTCGGCGCTGGCCTTGACCTCAGTTCATCTCCAGGTTTGACCTCGGATCAGGTAG >UAMH09666_KF466860_SSU GAAACTGCGAATGGCTCATTAAATCAGTTATAGTTTATTTGATAGTACCTTAACTACATGGATACCTGTGGTAATTCTAGAGCTAATACATGCTGAAAACCTCGACTTCGGAAGGGGTGTATTTATTAGATAAAAAACCAATGCCCTTCGGGGCTCGTTGGTGATTCATAATAACTTGTCGAATCGCATGGCCTTGCGCCGGCGATGGTTCATTCAAATTTCTGCCCTATCAACTTTCGATGGTAGGATAGAGGCCTACCATGGTGGCAACGGGTAACGGGGAATTAGGGTTCGATTCCGGAGAGGGAGCCTGAGAAACGGCTACCACATCCAAGGAAGGCAGCAGGCGCGCAAATTACCCAATCCCAATCCGGGGAGGTAGTGACAATAAATACTGATACGGGGCCCTTTCGGGTCTCGTAATCGGAATGAGAACAATTTAAACCCCTTAACGAGGAACAATTGGAGGGCAAGTCTGGTGCCAGCAGCCGCGGTAATTCCAGCTCCAATAGCGTATATTAAAGTTGTTGCAGTTAAAAAGCTCGTAGTTGACCCTTGGGCCTGGCTGGCCGGTCCGCCTCGCGGCGTGCACTGGTCCGGCTGGGCCTTTCCTTCTGGGGAGCCCCATGGCCTTCACTGGCTGTGGGGGGAACCAGGACTTTTACTGTGAACAAATTAGAGTGTTCAAAGCAGGCCTTTGCTCGGATATTTTTAGCATGGAATAATAGAATAGGACGTGTGGTTCTATTTTGTTGGTTTCTAGGACCGCCGTAATGATTAATAGGGATAGTCGGGGGCGTCAGTATTCGGCTGTCAGAGGTGAAATTCTTGGATTAGCTGAAGACTAACTACTGCGAAAGCATTCGCCAAGGATGTTTTCATTAATCAAGAACGAAAGTTAGGGGATCAAAGACGATCAGATACCGTCGTAGTCTTAACCGTAAACTATGCCGACTAGGGATCGGACGGGCAACTTTTAATAACCCGTTCGGCACCTTACGAGAAATCAAAGTCTTTGGGTTCTGGGGGGAGTATGGTCGCAAGGCTGAAACTTAAAGAAATTGACGGAAGGGCACCACCAGGCGTGGAGCCTGCGGCTTAATTTGACTCAACACGGGGAAACTCACCAGGTCCAGACAAAATAAGGATTGACAGATTGAGAGCTCTTTCTTGATCTTTTGGATGGTGGTGCATGGCCGTTCTTAGTTGGTGGAGTGATTTGTCTGCTTAATTGCGATAACGAACGAGACCTTAACCTGCTAAATAGCCCGGCCCACGTCTGTGGGCCGCCGGCTTCTTAGAGGGACTATCGGTGCAAGCCGATGGAAGTTTGAGGCAATAACAGGTCTGTGATGCCCTTAGATGTTCTGGGCCGCACGCGCGCTACACTGACAGGGCCAGCGAGTACATCACCTTGGCCGAGAGGTCTGGGTAATCTTGTTAAACCCTGTCGTGCTGGGGATAGAGCATTGCAATTATTGCTCTTCAACGAGGAATGCCTAGTAGGCACGAGTCATCAGCTCGTGCCGATTACGTCCCTGCCCTTTGTACACACCGCCCGTCGCTACTACCGATTGAATGGCTAAGTGAGGCCATCGGACCGGCCCAGGGAGGTTGGCAACGACCACCCCGGGCTGGAAAGTTGGTCAAACTTTGTCATTTAGAGGAAGTAAAAGTCGTAACAAGGTTTCCGTAGGTGAACCTGCGGAAGGATCATTA >UAMH09666_KF477204_SSU-LSU CATTACTGTTGGCTCCCGGGAGCGCCCTCGGGCACCCCGGACCCTCCACCCGTGTCTACCGAACCATATACTGCCTCGGCGGGCCCGTCTTCGGGCTGCTGGGACCCGCGGGCCTCCCCTCCAGCGATGGGGGCGGTGGTCCCCGGGCCCGGGCATGCGCCCGCCGCTGGCCCCCCTGAACTTCGTGAACAGTGAGCAGTCTGAGTGAGATTTTCAATCGTTTAAAACTTTCAACAATGGATCTCTTGGTTCCCGCATCGATGAAGAACGCAGCGAAATGCGATAACTAATGTGAATTGCAGAATTCCGTGAATCATCGAGTCTTTGAACGCACATTGCGCCCCCTGGTATTCCGGGGGGCATGCCTGTCCGAGCGTCATTGCACCCCTCAAGCACGGCTTGGTGTTGGGCGACCGTCCCCCGGGACGCGCCCCAAATGCATTGGCGGCACCGGCCCCGGTGTCCGGAGCGTATGGGAGACCTGTCACGCCCGTAGGACCCGGTCGGCGCTGGCCTTGACCTCAGTTCATCTCCAGGTTTGACCTCGGATCAGGTAG |
IMAGES: